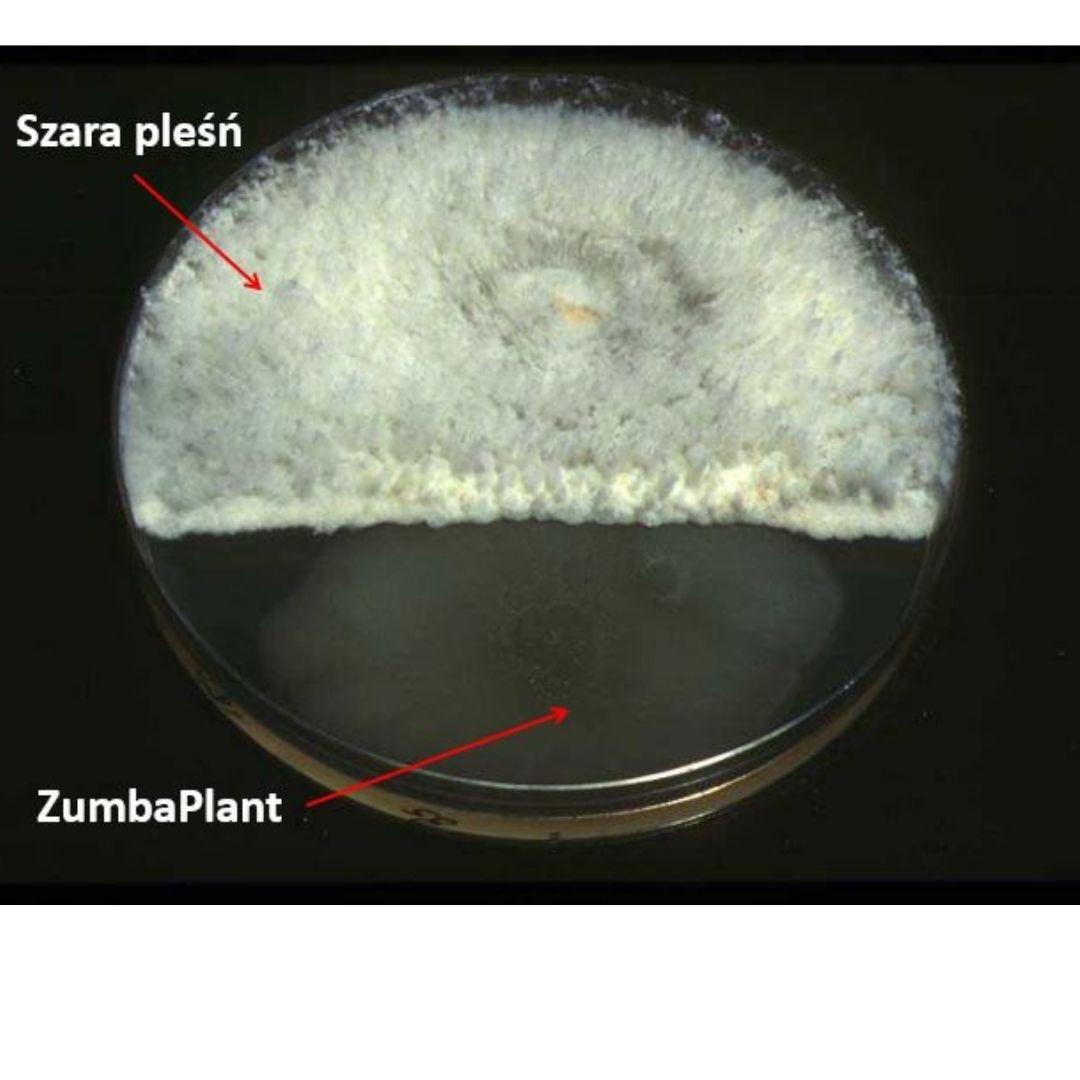

Zabiegi ograniczające występowanie szarej pleśni powinniśmy wykonywać od rozwoju kwiatostanu aż po koniec zbiorów. W celu zapobiegnia szarej pleśni zalecamy zastosować biologiczny aktywator odporności ZumbaPlant®, który zawiera wyselekcjonowany szczep Bacillus spp. ZumbaPlant posiada unikalny mechanizm działania wykorzystujący zjawiska antybiozy, konkurencji i indukcji odpornościowej. Produkt szybko namnaża się w środowisku, dzięki czemu konkuruje z chorobotwórczymi drobnoustrojami o pokarm i środowisko. Dzięki temu nie pozwala im rozwijać się na powierzchni roślin.
Stosowanie produktu najlepiej rozpocząć przed kwitnieniem i kontynuować do końca zbiorów. Zabiegi należy powtarzać co 7-10 dni w zależności od przebiegu pogody w programie integrowanym przemiennie z fungicydami. Do zabiegów ZumbaPlant należy dodać 1 l NaturalCrop SL. NaturalCrop SL zwiększa efektywność zabiegu, ponieważ zapewnia lepsze pokrycie liści, zwiększa odporność na zmywaniem oraz jest pożywką dla mikroorganizmów znajdujących się w ZumbaPlant.

ZumbaPlant jest wygodny w użyciu, ponieważ można stosować również na mokre rośliny np. z rosą lub po deszczu. Zawarty w produkcie szczep Bacillus spp. najefektywniej namnaża się w wilgotnym środowisku. Jest to szczególnie ważne, kiedy mamy często opady deszczu i trudno jest wykonać zabiegi. Ponadto ZumbaPlant jest całkowicie bezpieczny do stosowania pomiędzy zbiorami. W dniu zabiegu można zbierać owoce. Zabiegi wykonywane pomiędzy zbiorami powodują, że owoce są mniej podatne na pleśnienie. Dzięki temu truskawki są bardziej wytrzymałe na transport. Badania własne przeprowadzone w poprzednich latach potwierdzają , że ZumbaPlant wydłuża trwałość pozbiorczą owoców zarówno w temperaturze pokojowej jaki i chłodni.

 Więcej informacji na temat ZumbaPlant znajduje się w linku NaturalCrop - agronomia z natury - ZumbaPlant truskawka
Więcej informacji na temat ZumbaPlant znajduje się w linku NaturalCrop - agronomia z natury - ZumbaPlant truskawka